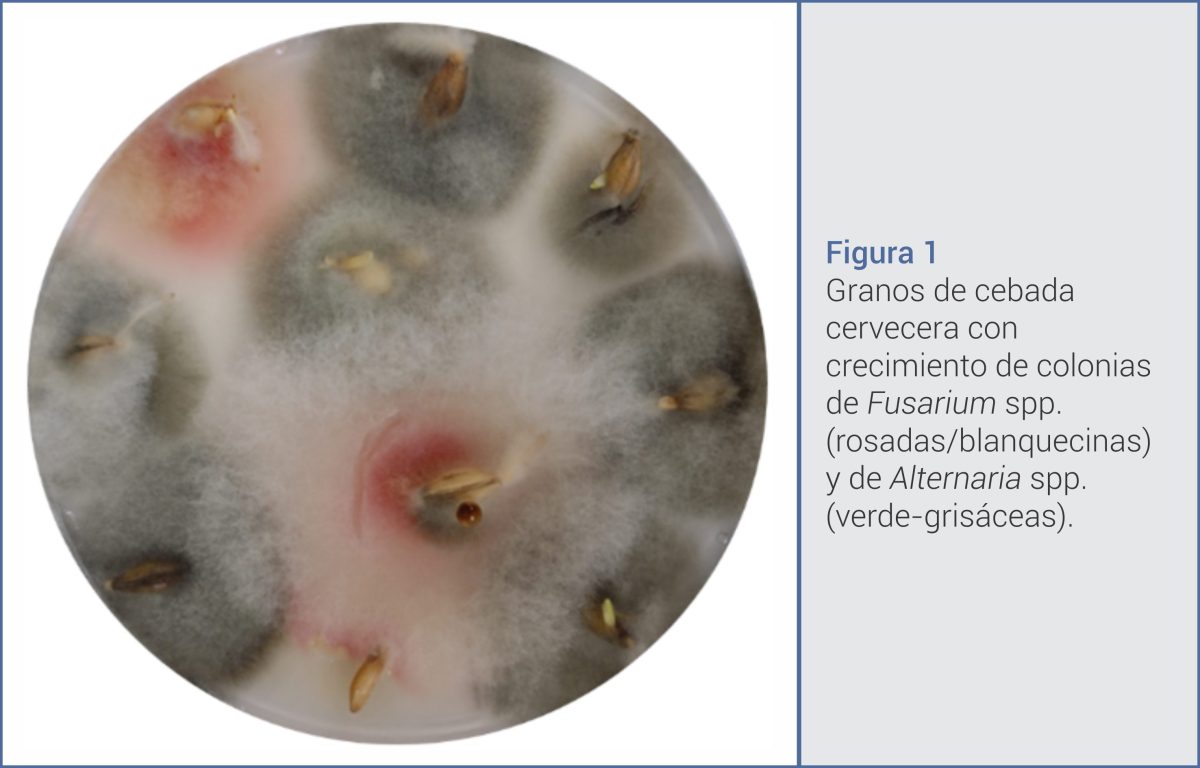

La cebada (Hordeum vulgare L.) es uno de los cereales estratégicos para la Argentina, tanto por su peso en la rotación agrícola como por su relevancia en la cadena cervecera y forrajera. Sin embargo, su calidad tecnológica e inocuidad pueden verse comprometidas por la presencia de hongos toxicogénicos y las micotoxinas que estos producen.
Un trabajo desarrollado por investigadores del Instituto de Biología Funcional y Biotecnología (BIOLAB Azul), de la Facultad de Agronomía de la UNCPBA, en articulación con la Red Nacional de Cebada Cervecera y el INTA, analizó muestras provenientes de la Chacra Experimental Integrada Barrow y de la EEA Bordenave del INTA durante las campañas 2020 y 2021. El estudio aporta evidencia local sobre la diversidad de especies de Fusarium y Alternaria, así como sobre la presencia de distintas micotoxinas en cebada cervecera.
Fusariosis de la espiga y deterioro de calidad
Entre los principales patógenos identificados se destaca la diversidad de especies del género Fusarium, responsables de la Fusariosis de la Espiga (FHB, por sus siglas en inglés). Esta enfermedad genera granos descoloridos, arrugados o abortados, con impacto directo en rendimiento y calidad comercial.
En Argentina, las especies más frecuentes en cebada son Fusarium graminearum y Fusarium poae (Nogueira et al., 2018; Piacentini et al., 2019). Además del daño productivo, estos hongos producen micotoxinas —principalmente tricotecenos— capaces de inhibir la síntesis de proteínas, ADN y ARN, afectar el sistema inmunológico y provocar trastornos gastrointestinales en humanos y animales.
Por su parte, especies del género Alternaria fueron predominantes en ambas localidades. Éstas afectan tejidos vegetales generando necrosis, pero además producen compuestos con potencial citotóxico, genotóxico y mutagénico. En cebada argentina se han identificado especies como A. tenuissima, A. arborescens, A. alternata, A. infectoria y A. vaccinii (Castañares et al., 2021).
La Figura 1 muestra granos con crecimiento de colonias de Fusarium (rosadas/blanquecinas) y Alternaria (verde-grisáceas), mientras que la Figura 2 presenta la observación microscópica de conidios de ambos géneros.

Diferencias entre localidades y campañas
Los resultados evidenciaron mayor diversidad de especies de Fusarium en Barrow. Allí se identificaron F. graminearum, F. poae, F. cerealis y el complejo Fusarium incarnatum-equiseti (FIESC) en ambos años; además, F. tricinctum solo en 2020 y F. acuminatum y F. chlamydosporum en 2021.
En Bordenave se detectó FIESC en las dos campañas, junto con F. graminearum y F. sporotrichioides en 2021. En cuanto a Alternaria, se identificaron cuatro especies en ambas localidades, con predominancia de A. infectoria en Barrow y de A. tenuissima en Bordenave (Figura 3).

Estas diferencias sugieren que las condiciones ambientales, las prácticas agronómicas y la composición de cepas presentes en cada campaña influyen en la dinámica de infección y en la producción de toxinas.
Micotoxinas: frecuencia y concentraciones
El análisis químico confirmó la presencia de múltiples micotoxinas (Tabla 1). La más frecuente fue deoxinivalenol (DON), detectada en ambas localidades y campañas. En 2020, el 100 % de las muestras de Barrow resultaron positivas para DON, con un máximo de 14,80 ppb; en Bordenave 2021, la positividad alcanzó el 100 %, con un máximo de 9,60 ppb.

También se detectó nivalenol (NIV), principalmente en 2020. En Barrow ese año se registró NIV en el 40 % de las muestras, con una concentración media de 178,7 ppb y un máximo de 317,80 ppb, los valores más elevados del estudio. Las especies productoras de NIV —como F. poae y algunas cepas de FIESC— estuvieron presentes en ambas campañas, lo que indica que factores ambientales específicos de 2020 habrían favorecido su síntesis.
Diacetoxiscirpenol (DAS) se cuantificó en las dos localidades y campañas, aunque con concentraciones menores. Además, se detectaron toxina T-2 (en una muestra de Barrow 2020) y fumonisina B1 (FB1) en Barrow 2021.
En cuanto a Alternaria, pese a su predominancia, solo se cuantificó alternariol monometil éter (AME) en una muestra de Bordenave 2020. Esto sugiere que las condiciones climáticas no habrían sido favorables para la producción significativa de toxinas de este género en los años evaluados.
Vacío regulatorio y necesidad de gestión
Actualmente, la normativa nacional no establece límites máximos de tolerancia para varias de las micotoxinas detectadas en cebada. Esta situación refuerza la importancia de contar con información científica local que permita dimensionar el riesgo y diseñar estrategias de manejo.
La co-ocurrencia de múltiples micotoxinas —DON, NIV, DAS, T-2 y FB1— plantea un desafío adicional, ya que los efectos combinados pueden potenciar la toxicidad, tanto en el consumo humano (industria cervecera) como en la alimentación animal.
Desde el punto de vista agronómico, los resultados subrayan la necesidad de fortalecer prácticas de manejo integrado: elección de cultivares, rotaciones, monitoreo sanitario, manejo de rastrojos y estrategias de cosecha y almacenamiento que minimicen la contaminación.
Un desafío para la cadena cebadera
La Argentina es un actor relevante en el mercado internacional de cebada, y la calidad sanitaria es un requisito creciente en los mercados. La evidencia generada en el sur bonaerense aporta datos concretos sobre la diversidad fúngica y el perfil toxicológico del grano, información clave para productores, asesores, malterías e industrias.
El estudio concluye que la presencia simultánea de Fusarium y Alternaria constituye una doble amenaza: productiva y sanitaria. Profundizar la investigación sobre su ecología, la influencia climática y la toxicidad combinada de sus metabolitos será determinante para avanzar hacia estándares de inocuidad acordes a las exigencias actuales.